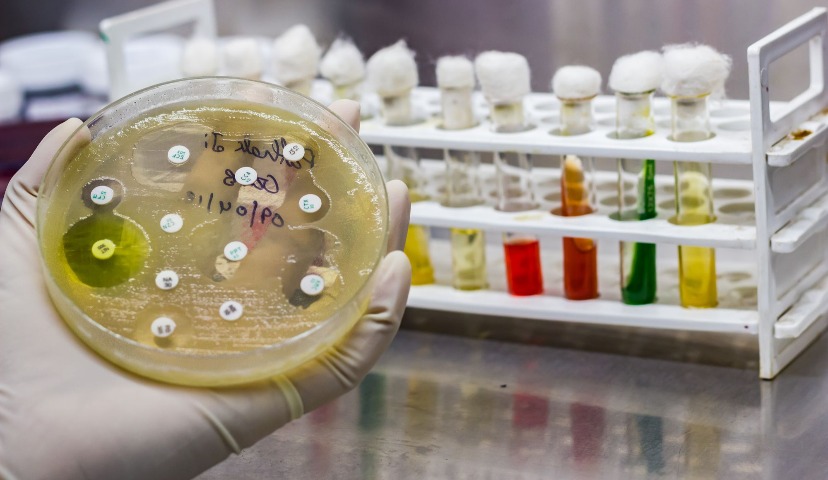
Животноводство без антибиотиков: утопия или реальность?

Животноводство без антибиотиков: утопия или реальность?
В недавнем интервью с разработчиком системы контроля антимикробных препаратов в ветеринарии и сельском хозяйстве, кандидатом ветеринарных наук Светланой Щепеткиной мы обсудили проблему антибиотикорезистентности и подробно рассказали о системе СКАМП, направленной на максимальное сокращение используемых в животноводстве антибиотиков.
Теперь узнаем, что думают об этой инициативе сами животноводы:
Сергей Зименко, директор ОАО «Батайское» – свиноводческого хозяйства, которое входит в мясной бизнес-комплекс «ГРУППЫ АГРОКОМ» (ГК «ТАВР»),
Елена Гуленкина, директор по маркетингу Группы компаний «Здоровая Ферма»,
Дмитрий Конев, исполнительный директор компании «Бизнес Фуд Сфера» – первого предприятия, сертифицированного в системе СКАМП (система контроля антимикробных препаратов).
Своим мнением с нами также поделился президент консалтинговой компании «АГРИФУД Стретеджис» Альберт Давлеев.
Сергей Зименко, директор ОАО «Батайское» – свиноводческое хозяйство, которое входит в мясной бизнес-комплекс «ГРУППЫ АГРОКОМ» (ГК «ТАВР»):
– Наше отношение к инициативе отказа от антибиотиков – положительное. Ее слабые стороны заключаются в неспособности противостоять остро-возникающим инфекционным заболеваниям. А также наличие у поголовья скрытых инфекций. В остальных случаях можно использовать препараты на основе растительного сырья, которые имеют антибактериальный эффект.
На сегодняшний день рынок насыщен препаратами, которыми возможно заменить часть антибиотиков, но не в полном объеме.
Исключить содержание антибиотиков в готовой продукции возможно, исключить их применение – нет. Отмечу, что антибиотики сегодня занимают порядка 80% всех применяемых в животноводстве лекарственных средств.
Таким образом, абсолютно доверять добровольной сертификации нельзя, ведь отсутствие антибиотиков в конечной продукции не означает, что их не применяли в процессе выращивания животных.
Частичный отказ от антибиотиков уменьшит себестоимость производимой продукции, но только если будут созданы идеальные условия по содержанию и кормлению поголовья.
Государственный контроль за содержанием антибиотиков, по нашему мнению, недостаточен, так как нет методик определения всех применяемых в животноводстве антибиотиков и их подгрупп.
Чувствительность существующих методов очень низкая. Исследования дорогостоящие. Проверить можно не на все группы антибиотиков, не говоря о подгруппах.
Елена Гуленкина, директор по маркетингу Группы компаний «Здоровая Ферма»:
– Как ответственный производитель Группа компаний «Здоровая Ферма» поддерживает идею о контроле наличия лекарственных препаратов в мясе, ведь в итоге потребитель получит качественную и безопасную продукцию. Мы положительно смотрим на данную инициативу, однако есть вероятность, что недобросовестные производители будут наносить данную маркировку, не пройдя соответствующих исследований и аккредитации в государственных ветеринарных органах.
Кроме того, надо сказать, что на промышленных животноводческих предприятиях, чтобы поддерживать и развивать производственные показатели, невозможно обойтись без лекарственных средств. Во-первых, используемые высокопродуктивные кроссы птицы и породы свиней генетически слабее и требуют поддержки в плане профилактики инфекционных заболеваний. Во-вторых, большой масштаб производства заставляет принимать превентивные меры, ведь если в стадо попадает одно заболевшее животное, теоретически под угрозу может попасть все поголовье, а это уже риски для бизнеса.
Сейчас, когда в разных регионах страны фиксируются вспышки птичьего гриппа, как никогда актуальным становится вопрос о тщательном контроле биобезопасности, создании оптимальных условий для кормления и содержания животных, автоматизации процессов.
Пробиотики и фитобиотики – альтернативные варианты, однако они увеличивают затраты и себестоимость продукта
Ответственные производители используют минимально возможное количество антибиотиков на начальном этапе выращивания животных, не допуская наличия остатков препаратов перед убоем. Как правило, период между прекращением использования антибиотиков и непосредственным убоем для птицы составляет две недели, для свиней – два месяца.
Перед убоем в организме животных не должно оставаться следов каких-либо антибактериальных препаратов, мясо на 100% должно быть безопасным. Контроль наличия остатков ветпрепаратов в конечном продукте системно осуществляет аккредитованная Россельхознадзором государственная лаборатория.
Сегодня около 90% промышленных производителей мяса используют в производстве лекарственные препараты. Остальная часть пользуется пробиотиками и фитобиотиками – альтернативными инструментами обеспечения здоровья животных. Однако при использовании альтернатив необходимо учитывать, что это увеличивает затраты и себестоимость продукта. При применении фитобиотиков необходимо снизить плотность посадки животных – это уменьшает выход мяса с одного кв. м. То есть исключение антибиотиков возможно, однако это приведет к удорожанию продукции.
Дмитрий Конев, исполнительный директор ООО «Бизнес Фуд Сфера» (компания образована на базе белгородского дивизиона холдинга «Белая птица»):
– В 2018 году мы смогли добиться более высоких производственных показателей, чем в 2017-м. Это стало возможно благодаря формированию правильного эпизоотического фона путем распределения необходимых схем вакцинаций по площадкам и повышению уровня биозащиты, что позволило снизить иммуносупрессию в организме птицы и приступить к реализации программы по отказу от применения антибиотиков. Программа предполагает замену антибиотиков в период интенсивного роста птицы на альтернативные препараты растительного происхождения, кислоты и пробиотики.
Добавлю, что программа реализуется в соответствии с поручением, Дорожной картой и Порядком, утвержденными губернатором Белгородской области Савченко Е.С., при содействии Управления ветеринарии Белгородской области, Департамента АПК Белгородской области и отраслевых экспертов.
На внедрение СКАМП было затрачено около 30 млн рублей
Организация системы контроля антимикробных препаратов (СКАМП) реализуется в рамках национальной Стратегии предупреждения распространения антимикробной резистентности в РФ до 2030 года, утвержденной распоряжением Правительства РФ. Сертификация в системе СКАМП означает, что на предприятии проведена большая работа и что выпускаемая продукция действительно не содержит антибиотиков. Ни одного миллиграмма и микрограмма.
«Бизнес Фуд Сфера» стало первым предприятием среди птицеводческих комплексов по выпуску продукции без антибиотиков, безопасной для человека. На сегодняшний день производится более 90 наименований продукции с такой маркировкой.
На внедрение СКАМП было затрачено около 30 млн рублей. При этом, затраты на внедрение системы контроля не отразятся на цене продукции.
Виталий Пономаренко, главный ветеринарный врач «Бизнес Фуд Сфера» и Дмитрий Конев, исполнительный директор «Бизнес Фуд Сфера»
Альберт Давлеев, президент консалтинговой компании «АГРИФУД Стретеджис»:
– Прежде всего, нужно понять, что имеется в виду: продукция «без антибиотиков / не содержит антибиотиков» или «выращено без антибиотиков». Если первое, то применение антибиотиков допускается, но они выводятся задолго перед убоем, поэтому в продукции не остаются. Если второе – то это, хотя и благородная, но весьма трудная задача, даже на кратком сроке откорма бройлера. Она требует серьезных и затратных средств биозащиты и биобезопасности, увеличения санразрывов, снижения плотности посадки, больше выбраковки птицы с симптоматикой, что в конечном итоге приведет к удорожанию конечной продукции. Не уверен, что «премия» от позиционирования такой курятины будет покрыта ценой реализации. В текущих условиях ведущие операторы розницы не видят значительной ценности в такой продукции. А потребители еще не совсем осознают опасность антибиотиков в мясе при покупке, ориентируясь, главным образом, на цену, дату производства или бренд.
Насколько увеличит затраты и усложнит жизнь участникам отрасли отказ от антибиотиков, зависит от конкретной ситуации в каждом конкретном хозяйстве. В целом, это может стоить компании от 10% до 100% обычной стоимости. Опять же многое зависит от полного или частичного отказа – в профилактических или терапевтических целях, или от тех и других.
Еще раз подчеркну, при полном исключении антибиотиков продукция будет минимум в 1,5 раза дороже обычной ввиду вынужденной отбраковки стад, к которым в терапевтических целях антибиотики все равно будут применяться, или из-за дороговизны откорма.
В настоящий момент вряд ли можно доверять системам добровольной сертификации производителей животноводческой продукции, поскольку большинство из них технически не отработаны, они недостаточно верифицированы, не публичны и не поддержаны государственными надзорными органами, которым доверяют больше – Россельхознадзором и Роспотребнадзором. Однако это не означает, что они на самом деле не вызывают доверия – просто они не «легитимизированы» официальными или публичными механизмами. Кроме того, нельзя забывать о нарастающем уровне скептицизма и недоверия к продуктам питания, в том числе мясу птицы, вызываемом негативными ТВ программами и публикациями в прессе.
Считаю ли я государственный контроль за применением антибиотиков и их остаточным количеством в готовой продукции достаточным и эффективным?..
За применением – нет, за остаточным количеством – скорее да, чем нет. Отсутствует система прослеживаемости лекарственных средств, как на уровне Таможенного союза, так и на территории РФ. Кроме того, требуется значительное усовершенствование лабораторной базы и квалификации персонала, как в Роспотребнадзоре, так и в Россельхознадзоре, поскольку одни и те же образцы порой дают совершенно разные результаты анализов. Связано это, прежде всего, с разобщенностью двух надзорных служб и отсутствием независимых арбитражных лабораторий, аккредитованных и сертифицированных не только в РФ, но и за рубежом по современным международно признанным методологиям.
Автор материала – Ирина Правская, руководитель направления разработки «Константа ИТ» Материал подготовлен совместно с партнером комьюнити по...
В пятницу, 20 марта 2026 года прошел форум АПК 360, где принимало участие много именитых и известных отраслевых деятелей и...
Материал подготовлен совместно с комьюнити Digital4food и Ириной Правской, руководителем направления разработки «Константа ИТ» И вот момент...
Парейдолия - это распространенная зрительная иллюзия, при которой мозг, стремясь распознать знакомые образы, «дорисовывает» базовые...
Новинки Останкино (ТМ "Папа Может", "Останкино", "Коровино") на выставке ПРОДЭКСПО 2026 ...
Коллеги цифровизаторы-интеграторы, айтишники и все умеющие отличать штрих-коды от...
Уважаемые коллеги здравствуйте. скажите пожалуйста кто уже подал заявку на участие в пилотном...
ну или креазот и деготь вам на стол для вашей печени. Фото снято в ноябре 2025...
Здравствуйте. Остаётся щетина после обесволашивания. Пробовали увеличение циклов, замену бил,...
Здравствуйте, уважаемые! Посоветуйте, пожалуйста. Предлагают по 80000 рублей две термокамеры...
Добрый вечер всем. Когда то писал письмо в ВНИИМП по данным книгам, которые они издавали, на...















Все это очень замечательно! и правильно!
Но приведет к тому, что на рынке останутся "монстры" мясной промышленности... Простой фермер или предприниматель просто не сможет конкурировать... Данный вопрос нужно решать на государственном уровне, причем не просто поставить в жесткие рамки регулятора, а субсидировать, хотя бы на альтернативные вет. препараты...